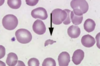
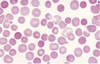

Apréndete la diferenciación célula de las lineas celulares:

Cual es la principal hormona estimulante de los megacariocitos?
Cual es la principal hormona estimulante de los eritrocitos?
Trombopoyetina
Eritropoyetina
Donde se produce la eritropoyetina?
En las células yuxtoglomerulares
Nota: ubicadas en las arteriolas aferentes de los glomérulos renales

Donde se originan los Progenitor linfoide comun (infocito) y donde maduran?
En medula ósea y de ahí migran al
Ganglio para poder madurar a Lin T o B
Que ocurre en el Sx anémico?
Descenso en hemoglobina
Que ocurre en el Sx febril?
Descenso en leucocitos (neutrofilos)
Que ocurre en el Sx purpúrico?

Descenso en plaquetas
La biométrica hemática se pone en tubo________ y contiene _______.
Morado
anticoagulante - Heparina
Sistema de medición que encuentra diferencia en la conductividad eléctrica de células y disolventes:
Recuento por impedancia (contar partículas en suspensión, como células, bacterias o glóbulos rojos, en un fluido)
Sistema de medición que hay una fuente de luz y las células pasan frente, un fotodiodo la convierte en impulsos eléctricos contables.
Detectores electroópticos
Apréndete los valores de la biométrica hematica:

Quiero sacar la hemoglobina, que formula debo usar?
Quiero sacar el hematocrito, que formula debo usar?
Eritrocitos x 3= Hemoglobina
Hemoglobina x 3= Hematocrito +- 3
Porcentaje de…
Plasma
Buffy coat (capa leucocitaria)
Eritrocito

Que analiza la amplitud de distribución eritrocitaria?
Que tanto se sale de la normalidad el tamaño de los eritrocitos de nuestra muestra. (11.5-14.5)
Como se determinan los indices eritrocitarios primarios y secundarios?
Nota: son parámetros que permiten evaluar la morfología y función de los eritrocitos
Primarios- Son determinados directamente en el laboratorio a través de pruebas de sangre.
Secundarios- Se calculan a partir de los índices primarios.
Que contiene los indices eritrocitarios primarios?
HB (Hemoglobina)
HTO (Hematocrito)
Número de eritrocitos/µl: La cantidad de glóbulos rojos presentes en un microlitro de sangre.
Que contiene los indices eritrocitarios secundarios?
CMHG (Concentración Media de Hemoglobina Globular): Mide la concentración de hemoglobina en una cantidad específica de glóbulos rojos.
VCM (Volumen Corpuscular Medio): Mide el tamaño promedio de los glóbulos rojos.
HGM (Hemoglobina Globular Media): Mide la cantidad promedio de hemoglobina en cada glóbulo rojo.
Valores de los indices eritrocitarios secundarios?
CMHG (Concentración Media de Hemoglobina Globular): 30-37
VCM (Volumen Corpuscular Medio): 80-95
HGM (Hemoglobina Globular Media): 27-34
Propósito de los indices eritrocitarios primarios y secundarios:
Primarios- Determinan si una persona tiene anemia (niveles bajos de hemoglobina o hematocrito) o policitemia (niveles altos de hemoglobina o hematocrito).
Secundarios- Indican el tamaño y el contenido de hemoglobina en los glóbulos rojos, lo que ayuda a clasificar diferentes tipos de anemia (microcítica, normocítica, macrocítica, etc.).
Que ocurre si tenemos VCM por debajo de 80?
Que ocurre si tenemos VCM por arriba de 100?
Microcitosis
Macrocitosis
Que ocurre si tenemos HCM (hemoglobina corpuscular media) por debajo de 27?
Anemia microciticas
Que ocurre si tenemos CHCM (concentración de hemoglobina corpuscular media) por debajo de 32 y arriba de 37?
Hipocromia
NO existe hipercromia
Cuales son las anemias microciticas hipocromicas?
Anemia ferropenica (deficiencia de hierro= no se puede producir hemoglobina= menos eritrocitos)
Talasemias (trastornos genéticos hereditarios que afectan la producción de hemoglobina)
Cuales son las anemias macrociticas?
Anemia megaloblastica (deficiencia de B12 o acido fólico)